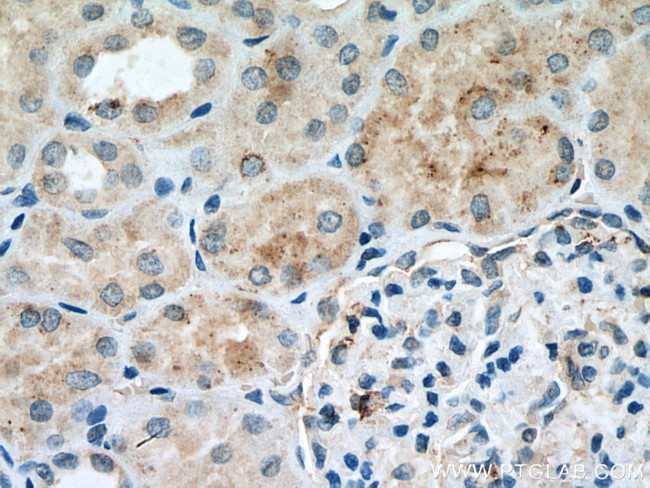
EPG5 Antibody in Immunohistochemistry (Paraffin) (IHC (P))

Search
Proteintech
EPG5 Polyclonal Antibody
{{$productOrderCtrl.translations['antibody.pdp.commerceCard.promotion.promotions']}}
{{$productOrderCtrl.translations['antibody.pdp.commerceCard.promotion.viewpromo']}}
{{$productOrderCtrl.translations['antibody.pdp.commerceCard.promotion.promocode']}}: {{promo.promoCode}} {{promo.promoTitle}} {{promo.promoDescription}}. {{$productOrderCtrl.translations['antibody.pdp.commerceCard.promotion.learnmore']}}
产品信息
27666-1-AP
种属反应
宿主/亚型
分类
类型
抗原
偶联物
形式
浓度
规格
纯化类型
保存液
内含物
保存条件
运输条件
产品详细信息
Immunogen sequence: ETRSMIVCLL FMMILLAKEV QLVDQTDSPL LSLLGQTSSL SWHLVDIVSY QSVLSYFSSH YPPSIILAKE SYAELIMKLL KVSAGLSIPT DSQKHLDAVP KCQAFTHQMV QFLSTLEQNG KITLAVLEQE MSKLLDDIIV FNPPDMDSQT RHMALSSLFM EVLMMMNNAT IPTAEFLRGS IRTWIGQKMH GLVVLPLLTA ACQSLASVRH MAETTEACIT AYFKESPLNQ NSGWGPILVS LQVPELTMEE FLQECLTLGS YLTLYVYLLQ CLNSEQTLRN EMKVLLILSK WLEQVYPSSV EEEAKLFLWW HQVLQLSLIQ TEQNDSVLTE SVIRILLLVQ SRQNLVAEER L
仅用于科研。不用于诊断过程。未经明确授权不得转售。
篇参考文献 (0)
生物信息学
蛋白别名: Ectopic P granules protein 5 homolog; ectopic P-granules autophagy protein 5 homolog; HEEW1 antibody; hEPG5 antibody; unnamed protein product
基因别名: 4732475F16; 5430411K18Rik; AI661957; AW456499; EPG5; HEEW1; KIAA1632; mKIAA1632; VICIS
UniProt ID: (Human) Q9HCE0, (Mouse) Q80TA9
Entrez Gene ID: (Human) 57724, (Mouse) 100502841